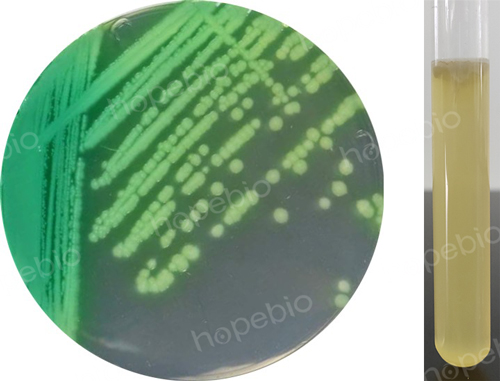

海博微信公众号
海博微信公众号
 海博天猫旗舰店
海博天猫旗舰店


 海博微信公众号
海博微信公众号
 海博天猫旗舰店
海博天猫旗舰店




在微生物世界中,存在着一类特殊的群体——产色素微生物。它们能够通过自身的代谢活动合成多种颜色各异的色素。这些色素不仅为微生物自身披上了绚丽的“外衣”,帮助它们在自然界中生存繁衍,还在医学、食品、工业等领域展现出重要的应用价值。从明亮的红色到深沉的紫色,从清新的绿色到温暖的黄色,产色素的菌如同自然界的“天然调色师”,用色彩描绘着微观世界的奇妙。
一、细菌家族中的色彩高手
细菌是产色素微生物中最庞大的群体之一,它们产生的色素种类丰富,如红色、黄色、紫色、蓝色等,多数色素具有较好的稳定性,在工业生产中具有广阔的应用前景,且不少与人类生活或健康密切相关。
1、紫色杆菌是细菌中的“紫色精灵”,其中最具代表性的是紫色色杆菌(Chromobacterium violaceum)。这种革兰氏阴性杆菌能产生一种名为紫色杆菌素的蓝黑色色素,让菌落呈现出独特的暗紫色。紫色杆菌素不仅是一种色素,还具有一定的抗菌活性,帮助紫色杆菌在复杂的自然环境中竞争生存空间。不过需要注意的是,紫色色杆菌是一种机会致病菌,当人体免疫力低下时,可能引发严重的感染,甚至导致败血病,因此在接触自然环境中的水体或土壤时需多加留意。除了它之外,深蓝紫色杆菌(Janthinobacterium lividum)、藤黄紫交替单胞菌(Alteromonas luteoviolacea)等细菌也能产生紫色杆菌素,在水体或海洋环境中扮演着“紫色使者”的角色。
紫色色杆菌的培养通常采用LB培养基或营养琼脂培养基。紫色色杆菌的最适培养温度为25℃-30℃,在固体培养基上培养24 h-36 h后,会形成圆形、光滑、湿润的菌落,菌落颜色初为乳白色,随后逐渐变为深紫色,且色素会分泌到培养基中,使培养基呈现出明显的紫色。在肉汤中,其液体表面与容器壁的接合处形成紫色环。该菌为兼性厌氧菌,在有氧条件下生长和色素合成情况更佳;若培养环境氧气不足,其生长速度会减慢,色素产量也会相应降低。
2、粘质沙雷氏菌则是细菌中的“红色代表”。这种革兰氏阴性短小杆菌堪称自然界的“迷你画家”,它能产生两种红色色素,脂溶性的灵菌红素让菌落呈现淡红色或粉色,水溶性的吡羧酸则会扩散到周围的培养基中,将其染成鲜艳的红色。粘质沙雷氏菌广泛存在于潮湿的环境中,浴室角落、马桶边缘都可能有它的身影。通常情况下,它对健康人群危害不大,但对于免疫力较弱的人来说,可能引发尿路感染、伤口感染等问题,因此保持生活环境的干燥清洁很重要。
粘质沙雷氏菌的培养通常采用营养丰富的培养基,以满足其生长和色素合成的需求。常用的培养基为营养琼脂培养基,粘质沙雷氏菌在营养琼脂培养基上生长良好,最适培养温度为25℃-30℃。在培养过程中,该菌最初形成的菌落为白色或淡黄色,随着培养时间的延长(通常培养24 h-48 h后),菌落会逐渐产生灵菌红素,颜色变为鲜艳的红色,且色素会扩散到培养基中,使周围的培养基也呈现出红色。值得注意的是,当培养温度超过37℃时,粘质沙雷氏菌的色素合成能力会显著下降甚至丧失,这是该菌培养过程中需要重点控制的条件之一。

图1 粘质沙雷氏菌在营养琼脂培养基平板上的生长形态
3、铜绿假单胞菌是细菌中的“绿色代表”,因能产生绿脓菌素而得名,这种色素会让感染部位的脓汁呈现绿色,因此它也被称为绿脓杆菌。作为常见的条件致病菌,铜绿假单胞菌广泛分布于自然界的土壤、水体中,当人体皮肤破损或免疫力下降时,可能侵入人体,引发呼吸道感染、皮肤软组织感染甚至败血症。绿脓菌素的产生是铜绿假单胞菌的重要特征,在医学诊断中,这种绿色的脓液往往是识别它的重要线索。
铜绿假单胞菌为需氧菌,在普通培养基上易于生长,培养适宜温度为35℃,pH值为7.2。普通琼脂上形成光滑,微隆起,边缘整齐波状的中等大菌落。由于产生水溶性的绿脓菌素(呈蓝绿色)和荧光素(呈黄绿色),故能渗入培养基内,使培养基变为黄绿色。普通肉汤均匀混浊,呈黄绿色。液体上部的细菌发育更为旺盛,于培养基的表面形成一层很厚的菌膜。
图2 铜绿假单胞菌在十六烷三甲基溴化铵琼脂平板及SCDLP培养基中的生长形态
4、金黄色葡萄球菌则是细菌中的“金色王者”。这种革兰氏阳性菌能产生脂溶性的金黄色色素,让菌落呈现出耀眼的金黄色,一眼就能从众多细菌中被识别出来。然而,这位“金色王者”并非善类,它是重要的病原菌,可引起疖、痈等化脓性感染,还能产生肠毒素,导致食物中毒,是食品卫生和临床治疗中需要重点防范的细菌之一。
金黄色葡萄球菌对高温有一定的耐受能力,在80℃以上的高温环境下30 min才可以将其彻底杀死,另外金黄色葡萄球菌可以存活于高盐环境,最高可以耐受15%浓度的NaCl溶液。由于细菌本身结构特点,利用70%的乙醇可以在几分钟之内将其快速杀死。金黄色葡萄球菌代谢类型为需氧或兼性厌氧,对环境要求不高,37℃为最适生长温度,能在各种恶劣环境中存活下来,因此,用一般的营养琼脂即可正常培养细菌。

图3 金黄色葡萄球菌在TSA上的生长形态
5、链霉菌是细菌家族中的“色彩魔术师”。作为一类革兰氏阳性细菌,链霉菌能产生红色、蓝色、黄色等多种色素,不同种类的链霉菌菌落色彩各异,仿佛微观世界的“调色盘”。链霉菌在抗生素生产中大名鼎鼎,许多常用抗生素都来自它们的代谢产物,而它们产生的色素也具有潜在的应用价值,目前已有研究探索其在食品着色、工业染料等领域的可能性。
二、真菌世界里的色素生产者
真菌同样是产色素的“能手”,其中一些种类产生的色素还被广泛应用于食品行业,与人类的日常生活息息相关。
红曲菌又称红曲霉菌是真菌中的“红色功臣”。这种丝状真菌在代谢过程中能合成红曲色素,包括红斑素、红曲红素等一系列化合物。红曲色素具有出色的稳定性和着色力,且安全性高,是一种天然的食用色素,被广泛用于腐乳、肉制品、糕点等食品的着色,让食物呈现出诱人的红色。除了作为色素,红曲菌发酵还能产生莫纳可林K等成分,具有降血脂的功效,因此红曲菌发酵制品在保健品领域也占有一席之地,是兼具实用价值和健康意义的真菌。
三、分枝杆菌中的“光影色素师”
分枝杆菌中的一些种类能根据光照条件产生不同的色素,堪称微生物中的“光影艺术家”。
1、堪萨斯分枝杆菌是典型的光产色菌。在黑暗环境中培养时,它的菌落呈现白色或奶油色,如同披着一层素净的“外衣”;但在光照条件下培养,它会产生色素,使菌落变成橘黄色或红色,仿佛在阳光下换上了鲜艳的“盛装”。这种特性让它很容易被鉴别,同时,堪萨斯分枝杆菌可引起人类肺结核样病变,患者会出现胸部疼痛、咳嗽、咯血等症状,在医学上需要引起重视。
2、瘰疬分枝杆菌则是暗产色菌的代表,无论在光照还是黑暗环境中培养,它的菌落都保持橘黄色或红色,仿佛一位始终穿着鲜艳“衣裳”的微生物。这种细菌常引起儿童的颈部淋巴结炎,也可能导致肺部或肺外感染及擦伤性脓肿等,在临床诊断中,其稳定的色素特征是识别它的重要依据。
四、相关产品
部分可培养产色素菌的培养基:
|
产品货号 |
产品名称 |
用途 |
|
HB0128 |
用于细菌增菌培养 |
|
|
HB0109 |
用于一般细菌培养、转种、复壮和增菌等 |
|
|
HB5184 |
用于绿脓杆菌的选择性分离培养(GB标准) |
|
|
HB5181 |
用于化妆品样品制备前增菌培养 |
|
|
HB0177 |
一种通用的营养培养基,用于各种微生物的培养, 也可用于阪崎肠杆菌的纯化培养和产黄色素试验。 |
注:本文属海博生物原创,未经允许不得转载。
下一篇:没有了!
| 相关文章: | ||



